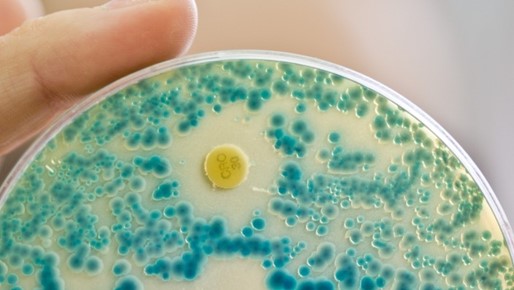

2019 yılında dünyada 1,2 milyonu aşkın insan antibiyotiğe dirençli hastalık etkenine bağlı bir enfeksiyon yüzünden yaşamını yitirdi. Bakteriler antibiyotik dirençliği geliştirdiklerinde, zararsız enfeksiyonlar da ölümle sonuçlanabilir. Uluslararası bir araştırma ekibi bu sorunun boyutunu inceledi. Tahminlere göre antibiyotik dirençliği dünya genelinde en sık görülen ölüm nedeni. Araştırma çerçevesinde 2019 yılına ait makaleler, hastane verileri, kontrol sistemleri ve diğer kaynaklar bir araya getirilerek, analiz edildi. İstatiksel modellerle veri bulunmayan farklı bölgelerin hastalık yükü de çıkartıldı.
Araştırmacılar toplamda 204 ülke ve bölge, 23 hasta edici bakteri ve 88 bakteri ve antibiyotik kombinasyonunu incelediler. Bunlar şimdiye kadarki en kapsamlı analizler. Araştırmaya göre 4,95 milyon ölüm vakası, antibiyotiğe dirençli bakterilere bağlı enfeksiyonla ilişkili, her ne kadar doğrudan ölüm nedeni başka olsa da. 1,27 milyon kişi dirençli bakteri enfeksiyonu yüzünden hayatını kaybetmiş, oysa antibiyotik dirençliği olmasaydı bu ölüm vakaları önlenebilirdi. Karşılaştırma için: 2020 yılında HIV/Aids yüzünden 680.000, sıtma yüzünden ise 627.000 kişi yaşamını yitirmiş. En çok da Batı Afrika’da, Sahra’nın güneyinde yaşayan insanlar etkilenmiş.
Burada antibiyotik dirençliğine bağlı ölüm oranı 100.000 kişide 24 olarak hesaplanmış. Gelişmiş ülkelerde bu oran 100.000 kişide 13. En çok da beş yaşının altındaki çocuklar tehdit altında. Özellikle de alt solunum yollarında dirençli bakteri enfeksiyonları çok etkili. Bu enfeksiyonlara bağlı olarak 400.000 kişi yaşamını yitirmiş. Dirençli patojenlere bağlı enfeksiyonlar, antibiyotiklerle tedavi edilemediği için, çok sayıda insan özellikle kan zehirlenmesi ve apandis yüzünden de yaşamını yitirdi. Direnç sorunlarına en sık neden olan mikroplar arasında Escherichia coli, Staphylococcus aureus, Klebsiella pneumoniae ve Streptococcus pneumoniae yer alıyor. Hastane mikrobu MRSA- metisiline dirençli Staphylococcus aureus- tek başına 100.000 ölüme neden olmuş. Son veriler antibiyotik dirençliğinin ne kadar büyük bir sorun olduğunu gösteriyor. Enfeksiyonların daha iyi hijyen ve aşılarla önlenmesi gerekir ve ayrıca gereksiz yere antibiyotik kullanımı da önlenmeli diyen araştırmacılar, yeni antibiyotiklerin geliştirilmesinin de çok önemli olduğunu vurguluyorlar.
Nilgün Özbaşaran Dede